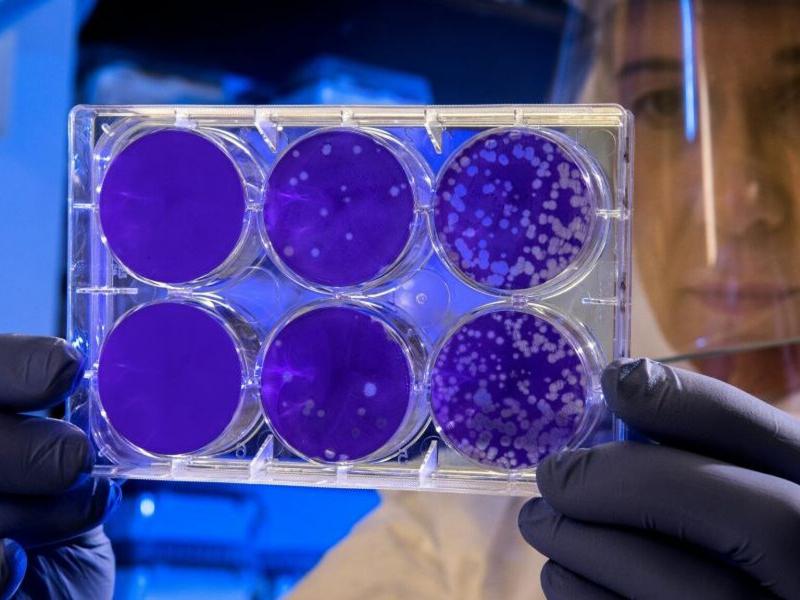
Εμφανίστηκε η θανατηφόρα νόσος Chagas

Μετά την πανδημία του κορονοϊού, νέα νοσήματα εξαπλώνονται σε διάφορα σημεία του πλανήτη.
Μάλιστα, η νόσος Chagas εμφανίστηκε στην Ανατολική Μεσόγειο.
Η νόσος Chagas παραμένει παγκόσμιο πρόβλημα δημόσιας υγείας λόγω της υψηλής νοσηρότητας και θνησιμότητας, όπως αναφέρει το thelancet.com.
Παρά τη δυνατότητα θεραπείας και τις προόδους στον έλεγχο της μετάδοσης, οι επιδημιολογικοί μετασχηματισμοί, όπως η αστικοποίηση και η παγκοσμιοποίηση, και η αναδυόμενη σημασία της στοματικής και κάθετης μετάδοσης σημαίνουν ότι η νόσος Chagas θα πρέπει να θεωρείται ως αναδυόμενη ασθένεια, με νέα κρούσματα να εμφανίζονται παγκοσμίως.
Σημαντικά εμπόδια στη διάγνωση, τη θεραπεία και την περίθαλψη παραμένουν, με αποτέλεσμα την καταστολή του αριθμού των αναφερόμενων περιπτώσεων, γεγονός που με τη σειρά του οδηγεί σε ανεπαρκείς δημόσιες πολιτικές.
Τα συμπτώματα
Η νόσος Chagas εμφανίζεται σε δύο φάσεις. Η αρχική οξεία φάση διαρκεί περίπου δύο μήνες μετά τη μόλυνση. Αν και μεγάλος αριθμός παρασίτων μπορεί να κυκλοφορήσει στο αίμα, στις περισσότερες περιπτώσεις τα συμπτώματα απουσιάζουν ή είναι ήπια και μη ειδικά (πυρετός, πονοκέφαλος, μεγέθυνση των λεμφαδένων, ωχρότητα, μυϊκός πόνος, δυσκολία στην αναπνοή, πρήξιμο και πόνος στην κοιλιά ή στο στήθος). Συχνά τα άτομα που δαγκώνονται από ένα μικρόβιο τριατομίνης εμφανίζουν τα χαρακτηριστικά πρώτα ορατά σημάδια, που είναι μια δερματική βλάβη ή ένα πορφυρό πρήξιμο στα βλέφαρα του ενός ματιού.
Κατά τη χρόνια φάση, τα παράσιτα κρύβονται κυρίως στην καρδιά και τους μύες του πεπτικού. Μία έως τρεις δεκαετίες μετά τη μόλυνση, έως και το ένα τρίτο των ασθενών υποφέρουν από καρδιακές διαταραχές και 1 στους 10 πάσχουν από πεπτικές (συνήθως διεύρυνση του οισοφάγου ή του παχέος εντέρου), νευρολογικές ή μικτές αλλοιώσεις. Στα επόμενα χρόνια αυτοί οι ασθενείς μπορεί να εμφανίσουν καταστροφή του νευρικού συστήματος και του καρδιακού μυός, επακόλουθες καρδιακές αρρυθμίες ή προοδευτική καρδιακή ανεπάρκεια και αιφνίδιο θάνατο.
Όλες οι σημαντικές και έκτακτες ειδήσεις σήμερα
Νέο Προσκλητήριο Προσλήψεων Εκπαιδευτών Ενηλίκων: Αφορά όλα τα πτυχία ΑΕΙ-ΤΕΙ - Πιστοποιηθείτε άμεσα
Παν.Πατρών: Tο 1ο στην Ελλάδα Πανεπιστημιακό Πιστοποιητικό ΤΕΧΝΗΤΗΣ ΝΟΗΜΟΣΥΝΗΣ για εκπαιδευτικούς
Πανεπιστήμιο Αιγαίου: Το κορυφαίο πρόγραμμα ειδικής αγωγής στην Ελλάδα - Αιτήσεις έως 14/9
Μοριοδοτούμενο σεμινάριο Ειδικής Αγωγής Πανεπιστημίου Πατρών με μόνο 60 ευρώ

Alfavita Newsroom
Alfavita Newsroom 



